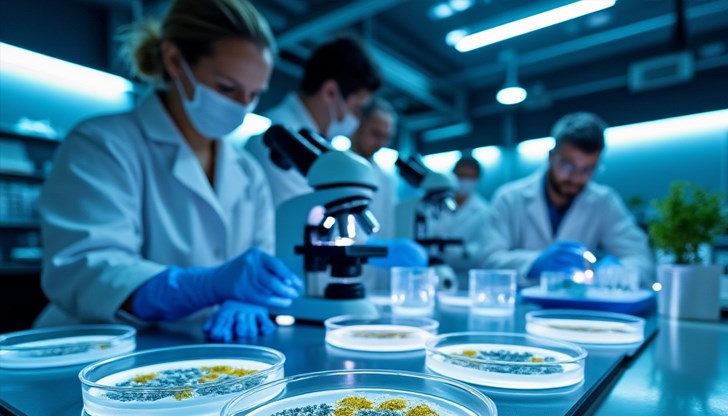
Учени откриха слабото място на резистентните бактерии

Революционно откритие в борбата с антибиотичната резистентност
- Редактор: Петя Георгиева
- Коментари: 0
Учени откриха слабото място на резистентните бактерии
Международен екип от учени направи пробив в изследването на бактериите, устойчиви на антибиотици, съобщава електронното издание Юрикалърт. Изследването разкрива неочаквана уязвимост при резистентните щамове, която може да промени подхода към лечението на бактериални инфекции.
Тревожни прогнози
Статистическите данни показват обезпокоителна тенденция - от 1990 година до 2021 година над един милион души годишно са загубили живота си поради резистентност към антибиотици. Според новите прогнози, до 2050 година броят на смъртните случаи ще се удвои, достигайки близо два милиона годишно.
Международно сътрудничество
Изследователски екип, воден от специалисти от Калифорнийския университет в Сан Диего, в партньорство с Аризонския щатски университет и висшето училище "Помпеу Фабра" от Испания, фокусира вниманието си върху бактерията Bacillus subtilis. Професор Гюрол Сюел и неговият екип от Факултета по биологични науки изследват парадоксален феномен при мутиралите варианти на бактерията.
Неочаквано откритие
"Открихме ахилесовата пета на бактериите, устойчиви на антибиотици", заявява професор Гюрол Сюел. "Можем да се възползваме, за да потиснем антибиотична резистентност без лекарства или вредни химикали".
Изследването, публикувано в Science Advances, разкрива, че антибиотичната резистентност има своята цена - въпреки че осигурява предимства за оцеляване, тя същевременно създава физиологични ограничения, които възпрепятстват пълното доминиране на резистентните щамове.
Глобален проблем
"Ефективните антибиотици са на изчерпване, а безразборната употреба през десетилетията е довела до разпространението им по целия свят - от Арктика до океаните и подпочвените води", обяснява Сюел. "Необходими са безлекарствени алтернативи за лечение на бактериални инфекции и наши проучвания показват как наистина можем да постигнем безлекарствен контрол над бактериите, устойчиви на антибиотици".

















